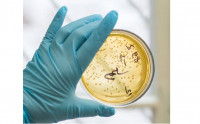

На Закарпатті за добу виявили 241 випадок COVID-19
241 новий випадок COVID-19 виявили на Закарпатті за минулу добу, 8 листопада. Такі дані повідомили на сайті Міністерства охорони здоров'я України. За добу 211 пацієнтів одужали, 8 людей з діагнозом COVID-19 померли.